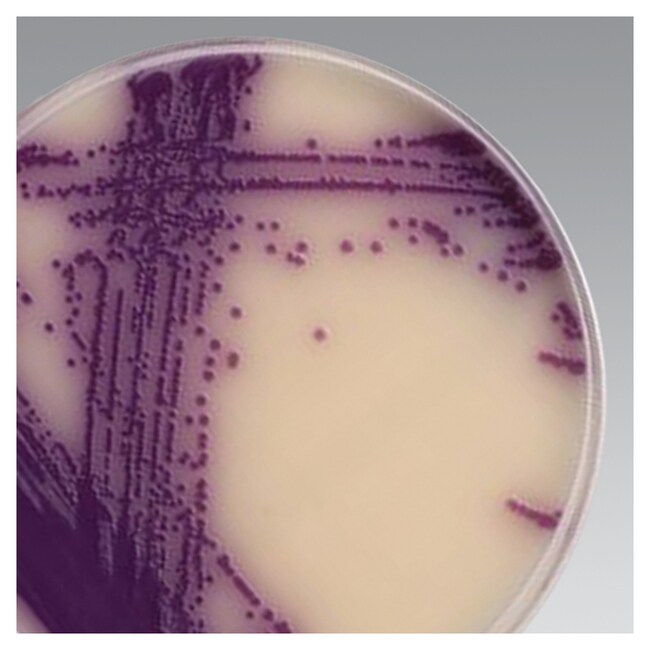
Brilliance&trade; 沙门氏菌琼脂基础培养基

Search
Thermo Scientific™
Brilliance™ 沙门氏菌琼脂基础培养基
使用该显色培养基从食品样品中分离并推定鉴别沙门氏菌属菌种。
| 货号 | 产量 |
|---|---|
| CM1092T | 可以配制 74 升培养基 |
| CM1092B | 可制得 9.3L 培养基 |
货号 CM1092T
价格(CNY)
-
产量:
可以配制 74 升培养基
采用 Thermo Scientific™ Brilliance™ 沙门氏菌显色琼脂基础培养基(脱水)从食品样品中分离并推测性鉴定沙门氏菌属菌种。
Inhibigen 化合物由两种组分组成,通过一种只有特定的酶才能切割的化学键结合在一起。结合在一起后,抑制剂化合物没有毒性,因此可以存在于培养基中而不会伤害微生物。进入细胞后,如果存在目标酶,则化学键将被切割。化学键切割后,抑制剂分子释放,并干扰细胞壁的合成,导致机体死亡。随着细胞的死亡和溶解,游离的抑制剂将被释放,但是无法被其他细胞吸收,从而导致靶向抑制。 Brilliance 沙门氏菌琼脂中的 Inhibigen 靶向 大肠杆菌。 将新生霉素和头孢磺啶以冻干补充剂 (SR0194) 形式添加至培养基中,以抑制其他竞争菌群的生长,如 变形杆菌属 菌种和 假单胞菌属菌种
沙门氏菌 与在 Brilliance 沙门氏菌琼脂上生长的其他微生物的鉴别通过包含两种同时靶向特定酶的发色剂实现:辛酸酯酶和 β-葡萄糖苷酶。辛酸酯酶是一种在所有沙门氏菌和某些 克雷伯菌属、 肠杆菌属 和 变形杆菌属中存在的酶。具有辛酸酯酶的微生物可以切割发色剂,释放不可溶的紫色发色团。随着细胞的生长,发色团积聚,从而产生紫色的菌落。某些肠杆菌科(包括 克雷伯菌属 和 肠杆菌属 ,但是不包括 沙门氏菌属)具有 β-葡萄糖苷酶 2。如果这些微生物生长,它们会形成蓝色或深蓝色的菌落(即使它们呈酯酶阳性),使它们很容易与紫色沙门氏菌菌落区分开来。
另外还提供沙门氏菌属选择性添加剂,货号 SR0194E。
规格
描述Brilliance™ 沙门氏菌显色琼脂基础(干粉)
数量单件
产量可以配制 74 升培养基
形式Powder
产品类型Media Broth
种属Salmonella
Unit SizeEach